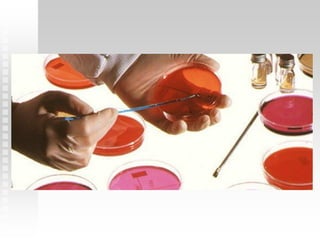

O documento descreve os materiais e instrumentos de laboratório mais comuns, suas funções e normas de segurança para seu uso, listando e explicando equipamentos como provetas, pipetas, balões de destilação, becos e suportes utilizados em análises clínicas.